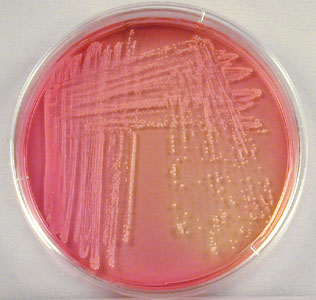
Staphylococcus saprophyticus Growing on Mannitol Salt Agar - Staphylococcus saprophyticusgrowing on Mannitol Salt Agar (Image source: Gary E. Kaiser)

Staphylococcus saprophyticus is one of the pathogenic species of staphylococci, the other two are S. aureus and S. epidermidis. Staphylococcus epidermidis and S. saprophyticus are often referred to as coagulase-negative staphylococci (CONS).

Staphylococcus saprophyticus causes urinary tract infections (UTI), especially cystitis in sexually active young women. The organism is second to Escherichia coli as a cause of community-acquired urinary tract infections in young women.
General Features
- In Gram staining, Staphylococcus saprophyticus appears as Gram-positive cocci in clusters.
- Coagulase production: No
- Typical hemolysis: None
- Resistant to novobiocin in contrast to S. epidermidis which is sensitive.
- Causes community-acquired UTI in young women.
Transmission
Staphylococcus saprophyticus is a normal flora of the perineum, rectum, urethra, cervix, and gastrointestinal tract. It**is found primarily on the mucosa of the genital tract in young women and from that site can ascend into the urinary bladder to cause urinary tract infections. Most women with this infection have had sexual intercourse within the previous 24 hours. Patients usually present with dysuria, pyuria, and hematuria.
Laboratory Diagnosis
Sample: Clean-catch mid-stream urine sample.
Find detailed information about theurine sample collection procedure here.
Colony Morphology in 5% sheep blood agar
S. saprophyticus usually gives white colonies in blood agar, but colonies can be yellow to orange. Colonies are large; entire, very glossy, smooth, opaque, butyrous, and convex.
Urine culture: Though a positive urine culture is indicated by the presence of 100,000 colony-forming units per mL, S. saprophyticus is usually present in quantities less than or equal to 100,000 cfu/mL, but will be detected in sequential specimens.
If significant bacteriuria of gram-positive cocci is seen, the organism is identified by performing catalase and coagulase test. Suppose the organism is catalase-positive and coagulase-negative, novobiocin test should be performed to differentiate S. epidermidis from S. saprophyticus. If the organism is sensitive to novobiocin, it is S. epidermidis, most likely to be the contaminant (normal flora).
If the organism is novobiocin-resistant, it is identified asS. saprophyticus. It is a pathogen for women of the reproductive age group, so antimicrobial testing should be performed, and the antibiogram result should be reported to the physician.
Biochemical Tests forStaphylococcus saprophyticus
| Name of the test | Test Result |
|---|---|
| Catalase test | Negative |
| Coagulase test | Negative |
| Novobiocin sensitivity test | Resistant |
| Mannitol fermentation | Yes |
| PYR broth hydrolysis test | Negative |
| Urease test | Positive |
| Oxidase test | Negative |
| Alkaline phosphatase test | Negative |
| Acid From D-Trehalose | Positive |
| Maltose fermentation | Yes |
| Sucrose fermentation | Yes |
| D-Mannose fermentation | No |
Treatment
Staphylococcus saprophyticus urinary tract infections can be treated with trimethoprim-sulfamethoxazole or a quinolone, such as ciprofloxacin.